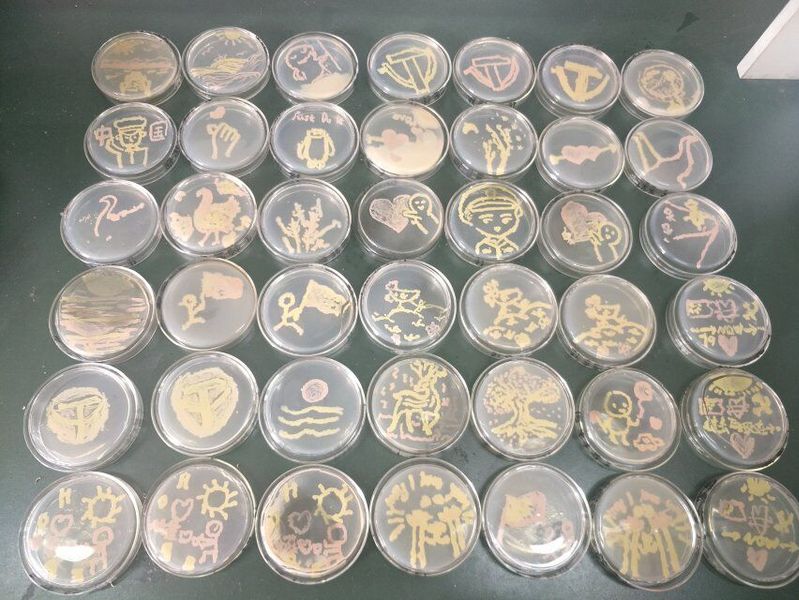

(本网讯)近日由校团联会主办,生化学院团委、化学科技协会、生物与健康协会(筹)承办的校首届微生物培养皿艺术大赛落幕。

本次比赛分为初赛、复赛、决赛三个阶段,历经一个多月,参与学生数达到500余人。初赛用笔试选拔,成绩优异者进入复赛。复赛选手按照指定的菌种和指定的图案在培养基上作画,选拔操作技术好、作品质量优异的参赛者进入决赛。决赛选手根据自己准备的设计稿,选用所提供的菌种自主作画,并对自己的作品进行阐述,经评委老师现场打分确定比赛结果,分别产生了一等奖2名、二等奖4名、三等奖6名及优秀奖2名。本次比赛过程中创作出许多优秀的作品,有灵动活泼的小鹿,有让人肃然起敬,严肃又不失可爱的警察叔叔,还有熙熙攘攘,坠满枝头的樱花树。选手们通过色彩的搭配,熟练的操作技巧创作出了一幅幅美丽生动的微生物图画。
通过此次比赛,加深了同学们对奇妙的微观世界的认识,增强了同学们探索微观世界奥秘的兴趣,培养了同学们的思维创造力和实际动手能力,营造了良好的校园文化氛围。

(文:钱森和、邵佳雯;图:李佳雪、潘玲;审核:王辉;编辑:徐征)
